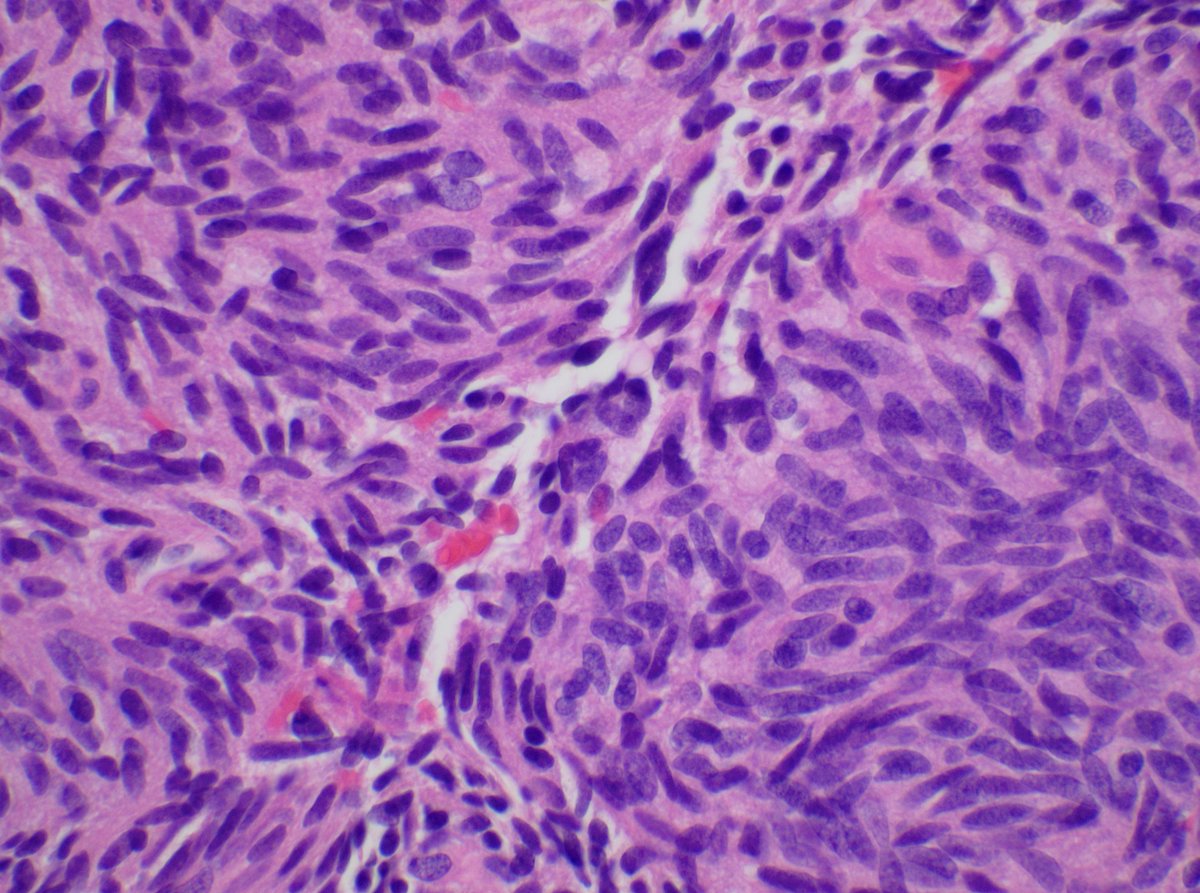

Saadiya Nazli, MD, BSc, QIA(ASCP)
@docsaadiya
PGY-2 AP/CP, Former Cell Therapy Fellow @MayoClinic
Transfusion Medicine, Therapeutic Apheresis & Cellular Therapies. Former Apheresis Physician @KSUMedicalCity
ID: 1281939169
20-03-2013 00:53:09
874 Tweet
582 Followers
623 Following

Congratulations Dr. Burak Tekin for receiving ISUP stipend award🏆 and amazing poster sessions. Dr. Tekin is our outstanding🏅GU fellow and incoming faculty at Mayo Clinic Burak Tekin Sounak Gupta Rumeal D. Whaley, MD Ryan Kendziora #USCAP #Boston




Very thrilled of today's Mayo Research Fellows’ Association (MRFA) poster presentation. It is great to witness all of the great projects happening at Mayo Clinic! It was exciting to share the advances of our current study!🐀🔬 Special thanks to my amazing team for their guidance!




Metastatic renal cell carcinoma is really a sneaky thing. This example produced a duodenal submucosal lesion - at first glance it resembles Brunner glands. #UMiamiPath Modern Pathology Innovative Science Press



5 fellows of the Mayo Clinic Cell therapy fellowship program numbered and lined up at ISCT with program director Dr. Eapen Jacob! Proud to be Alumni of the program college.mayo.edu/academics/resi… Dr. Ashley Krull, Ph.D. ISCT Shannon Strader, DO, MS #ISCT2025 #NewOrleans